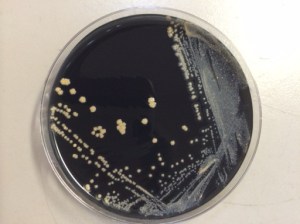
Isolated growth on BCYE media.

Clinical History
A 55 year old male with a 43-pack-year smoking history was transferred to our hospital for evaluation of new onset neurologic deficits including slurred speech, aphasia, and right upper extremity diminished dexterity and neglect. CT chest was remarkable for a mass in the superior segment of the left lower lobe. Needle core biopsy of the lung mass revealed poorly differentiated non-small cell carcinoma. Head MRI demonstrated an enhancing mass in the left frontoparietal junction that was concerning for metastasis from a lung primary. The patient was started on chemotherapy as an outpatient. Follow-up imaging showed growth of the brain mass. A biopsy of the brain mass showed no evidence of metastasis, only “reactive brain with foci of dense mixed inflammation and filamentous bacteria consistent with abscess.”

Laboratory Findings
A portion of the brain biopsy was submitted for bacterial smear and culture. The aerobic culture grew chalky white colonies that, when stained with modified acid-fast stain, showed modified acid-fast positive filamentous bacteria, suspicious for Nocardia spp. Bacteria of similar morphology were also seen in the surgical pathology specimen when stained for modified AFB and with GMS.


Disscussion
Nocardia is a genus of aerobic, catalase positive, saprophytic bacteria often found in the environment, but that can also be considered as normal flora on skin and in the respiratory tract. Nocardia species are variably acid-fast; for proper identification they must be stained with a modified acid-fast procedure (Fite, Kinyuon), using a weaker decolorizing acid. Nocardia will be negative by traditional acid-fast staining procedures (Ziehl–Neelsen). When Gram stained, Nocardia will appear as branching filamentous gram-positive bacilli with a “beaded” staining pattern (as if a string of beads).
Multiple species are considered human pathogens, including N. asteroides, N. brasiliensis, N. cyriacigeorgica, N. farcinica, and N. nova. These organisms can cause disease in immunocompromised patients if inhaled or inoculated via trauma. If there is an established pulmonary infection, Nocardia may spread hematogenously, often infecting the brain.
Central nervous system nocardiosis may occur in any region in the brain and can present with mass effect symptoms without typical infectious symptoms, as in our patient. Prognosis varies based on the extent of disease and the cause of a patient’s immunosuppression. Treatment of CNS nocardiosis usually begins with an induction phase of intravenous TMP-SMX and imipenem for 3-6 weeks or until there is clinical improvement. Once the patient improves, they can be switched to oral therapy with a sulfonamide and/or minocycline and/or amoxicillin-clavulanate.
References
- Beaman BL. Nocardia Species : Host-Parasite Relationships. 1994;7(2):213-264.
- Spelman D. Clinical manifestations and diagnosis of nocardiosis. In: Sexton DJ, Mitty J, eds. UpToDate. UpToDate, Inc.
- Spelman D. Microbiology, epidemiology and pathogenesis of nocardiosis. In: Sexton DJ, Mitty J, eds. UpToDate. UpToDate, Inc.
- Spelman D. Treatment of Nocardiosis. In: Sexton DJ, Mitty J, eds. UpToDate. UpToDate, Inc.
- Tille, Patricia M., PhD, BS, MT(ASCP) Facs. Bailey & Scott’s Diagnostic Microbiology. 14th ed. Elsevier; 2017.
-Michael Madrid, MD is a 1st year Anatomic and Clinical Pathology Resident at the University of Vermont Medical Center.

-Christi Wojewoda, MD, is the Director of Clinical Microbiology at the University of Vermont Medical Center and an Associate Professor at the University of Vermont.